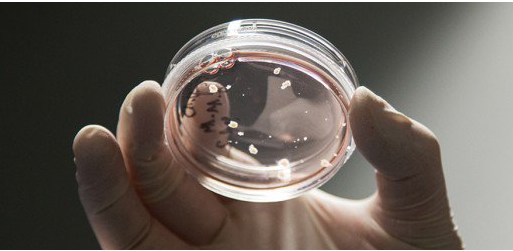

|
|
发表于 2022-4-2 12:54:40
|
查看: 171 |
回复: 0
精神分裂症始于妊娠早期是怎么回事,是真的吗?2018年01月18日是本文发布时间是这个时间。下面一起来看看到底怎么回事吧。
精神分裂症始于妊娠早期
研究者利用体外培养的“迷你脑”,研究大脑发育中的问题。
精神分裂症状常见于青少年,但一项新的研究显示,这种大脑疾病可能早在妊娠早期,即母亲孕期的前三个月,便开始发生。该发现为理解这一破坏性疾病打开新的大门,并为进行子宫内治疗提供新的可能性。
该项研究的领导者、纽约州立大学布法罗分校雅各布医学及生物医学学院的病理及解剖学教授 Michal K. Stachowiak 称,该研究为精神分裂症始于胎儿发育早期提供有力证据。“这疾病已被误解近4000年,”他讲道,首次关于精神分裂症的描述据信出现在公元前1550年的埃及医学文章《埃伯斯莎草纸文稿》(Ebers Papyrus)上。
“多个世纪以来病人接受着残酷的治疗,甚至囚禁,后来又被认为精神和道德价值方面的疾病,或者由父母的恶劣影响所致(于1975年开始出现在精神病教科书里的概念),我们现在终于有证据表明精神分裂症是一种大脑形成及结构发生根本性改变所致的精神失调症,” Stachowiak 说道。
该项研究基于 Stachowiak 和其同事之前的发现,虽然不同病人的精神分裂症涉及数以百计个基因突变,但它们集中在一条名为“整合核 FGFR1 信号通路 (INFS)”的基因组错误通路上。今年早些时候UB 的研究者们报道过这一通路。但该通路什么时候、如何出现调节异常,并且如何影响脑部发育并不为人们所知晓。
Stachowiak 和同事,也是他的配偶、病理及解剖学助理教授 Ewa Stachowiak 采用迷你脑技术,一种体外培养的微型脑结构,称作大脑类器官(cerebral organoids)。“我们希望,从某种意义上能够阐明在子宫内大脑形成的重要阶段。”Stachowiak 讲道。
在早前发表的文章中,UB 的研究人员与来自西奈山医院伊坎医学院(Icahn School of Medicine atMt. Sinai)的 Kristen J. Brennand 描述道,他们设计了对照组(三位普通人)和实验组(四位精神分裂患者),使用从中取得的皮肤细胞,将迷你脑结构重编入诱导性多能干细胞(induced pluripotent stemcells,iPSCs)。Stachowiak解释说,在发育的胚胎中,表皮细胞能发育成皮肤或大脑等组织或器官。
“我们在实验室中利用干细胞模仿这一进程,尤其致力于培养大脑类器官,模仿大脑发育的初期阶段,”他说道。UB 的学者们更改了最近一份关于体外培养早期脑部结构的实验方案。
多个星期以来,研究者用营养物质、葡萄糖、酸及生长因子来培育干细胞,以促进所谓的胚状体的发育和形成,胚状体属于组织开始分化时第一个可识别的阶段。通过添加培养基,营养物质及生长因子,它们最终成长为形成大脑的组织——“神经外胚层”。
随后,这些神经外层细胞被移出来,置于一个含不同培养基及化学和营养物质供应的环境中,并一直处于频繁活动的状态,最终发展成为类脑器官,或称迷你脑。这些迷你脑包含脑室,脑皮质以及一个类似脑干的区域。
“这一阶段,我们在精神分裂症病人‘迷你脑’的皮质中发现了严重的畸形,”Stachowiak 说道。的确如此,他补充说,因为最近有越来越多的证据将精神分裂症与皮质中的功能异常联系在一起,而作为大脑中最大的一部分,皮质负责一些关键功能,包括记忆,注意力,认知,语言以及意识。
他们发现某些种类的神经祖细胞(将来回发育成神经元)在病人“迷你脑”皮质中呈现不正常的分布。对比皮质外的区域有着大量成熟的神经元,在皮质内则十分罕见,Stachowiak 解释道。
“我们的研究显示,疾病很可能开始于胚胎形成的头三个月,并涉及细胞的加速分裂、过度迁移以及神经外胚层细胞过早分化为神经元,”他说道。“负责连接皮质不同区域的神经元,即所谓的中间神经元,在精神分裂症患者的大脑皮质中被错误引导,导致皮质区域出现错误连接,如同一台接错线的电脑。
“现在,我们可以说精神分裂症是一种大脑结构缺陷失调症,发生在胚胎发育早期,相当于母亲怀孕的最初三个月,且涉及皮质中特定的神经元回路畸形。”他称道。这个实验展示了INFS通路上的错误调节导致大脑细胞无法建立某些基因网络连接,并最终发展成疾病。
“下一步将研究如何通过相关药物甚至饮食增补剂影响 INFS 通路及相关通路,从而定位异常基因以预防调节紊乱的发生,”他答道,并指出这类的补充治疗已经能有效应用于某些疾病,例如脊柱裂(spina bifida)。
Stachowiak 指出,他们建立的大脑类器官模型已证实能用于其他疾病。国家自然科学基金(National Science Foundation)资助 Stachowiak 和工程及应用科学学院电子工程系的副教授 Josef M. Jornet,帮助他们利用这些模型来探索脑机接口,一种最终能有效指导创伤或中风后大脑组织再生的治疗方案。
“我们试图把‘迷你脑’研究与智能纳米光子设备结合起来,以发展新一代的脑机接口,”Stachowiak 解释道。“有了这项技术,我们也许最终能够控制并修正发育的大脑中复杂组织的细胞生长。发展该类技术的重要一步在于大脑类器官或迷你脑测试,观察它们是否真的能实时地引导和纠正脑部发育。”
作者 Ellen Goldbaum
翻译 梁珩
审校 阿金
原文链接:http://www.buffalo.edu/news/releases/2017/11/026.html |
|